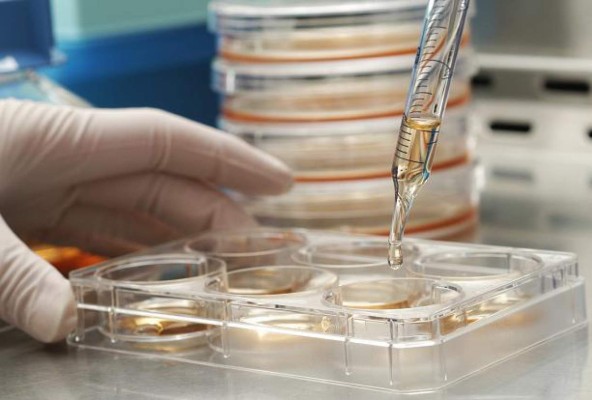
Científicos nipones logran regenerar células nerviosas con células híbridas

Tokio, Japón
Científicos japoneses han desarrollado una célula artificial híbrida que combina células pluripotentes inducidas (iPS) con células nerviosas artificiales, y que podría ayudar a desarrollar tratamientos menos invasivos que los actuales.
El hallazgo ha sido llevado a cabo por un grupo de investigadores del Hospital Universitario de Osaka (oeste de Japón) que ya ha probado con éxito las células híbridas en ratones, informó el diario japonés 'Asahi'.
Para desarrollarlas, el equipo creó en primer lugar una célula nerviosa artificial que sirviera como base.
Los científicos llevaron a cabo una serie de agujeros en polímeros tubulares para facilitar la ubicación de las células.
Entonces, convirtieron células iPS en células progenitoras cerebrales que pueden desarrollarse en varios tipos de tejido nervioso y las juntaron con las artificiales.
Las células híbridas se trasplantaron en un ratón que había sufrido daños nerviosos en las patas traseras.
Unos seis meses después del trasplante, los investigadores descubrieron cerca de 200 hilos conectados con el núcleo de las células nerviosas, unas cuatro veces más que el número de hilos que se encuentran en las células nerviosas artificiales normales.
Los investigadores quieren realizar más pruebas sobre sus hallazgos, que según el diario nipón se publicarán dentro de poco en una revista médica de Estados Unidos, con la esperanza de que las células nerviosas híbridas puedan utilizarse en humanos dentro de cinco años.
Los procedimientos actuales para tratar los daños nerviosos pasan por llevar a cabo un trasplante de células nerviosas de otras partes del cuerpo del paciente, un método que puede causar entumecimiento en las zonas de las que se toman las células.
Otro tratamiento emplea células nerviosas artificiales con forma de tubo para favorecer la regeneración de las células, sin embargo, la efectividad de la técnica es limitada.
Científicos japoneses han desarrollado una célula artificial híbrida que combina células pluripotentes inducidas (iPS) con células nerviosas artificiales, y que podría ayudar a desarrollar tratamientos menos invasivos que los actuales.
El hallazgo ha sido llevado a cabo por un grupo de investigadores del Hospital Universitario de Osaka (oeste de Japón) que ya ha probado con éxito las células híbridas en ratones, informó el diario japonés 'Asahi'.
Para desarrollarlas, el equipo creó en primer lugar una célula nerviosa artificial que sirviera como base.
Los científicos llevaron a cabo una serie de agujeros en polímeros tubulares para facilitar la ubicación de las células.
Entonces, convirtieron células iPS en células progenitoras cerebrales que pueden desarrollarse en varios tipos de tejido nervioso y las juntaron con las artificiales.
Las células híbridas se trasplantaron en un ratón que había sufrido daños nerviosos en las patas traseras.
Unos seis meses después del trasplante, los investigadores descubrieron cerca de 200 hilos conectados con el núcleo de las células nerviosas, unas cuatro veces más que el número de hilos que se encuentran en las células nerviosas artificiales normales.
Los investigadores quieren realizar más pruebas sobre sus hallazgos, que según el diario nipón se publicarán dentro de poco en una revista médica de Estados Unidos, con la esperanza de que las células nerviosas híbridas puedan utilizarse en humanos dentro de cinco años.
Los procedimientos actuales para tratar los daños nerviosos pasan por llevar a cabo un trasplante de células nerviosas de otras partes del cuerpo del paciente, un método que puede causar entumecimiento en las zonas de las que se toman las células.
Otro tratamiento emplea células nerviosas artificiales con forma de tubo para favorecer la regeneración de las células, sin embargo, la efectividad de la técnica es limitada.